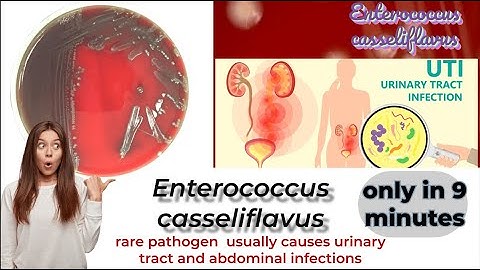
enterococcus microbiology lecture ||enterococcus casseliflavus ||Easy Microbiology

⬇ DOWNLOAD NOW
Kalau muncul iklan pop-up, tutup lalu klik tombol kembali
Download lagu enterococcus microbiology lecture ||enterococcus faecium||Easy microbiology secara gratis hanya untuk keperluan promosi. Dukung artis favorit kamu dengan membeli musik original di iTunes atau platform resmi lainnya.
 enterococcus microbiology lecture ||enterococcus ||Easy microbiology
enterococcus microbiology lecture ||enterococcus ||Easy microbiology
 enterococcus microbiology lecture ||enterococcus faecalis ||Easy Microbiology
enterococcus microbiology lecture ||enterococcus faecalis ||Easy Microbiology
 Enterococcus- causes, symptoms, diagnosis, treatment, pathology
Enterococcus- causes, symptoms, diagnosis, treatment, pathology
 enterococcus microbiology lecture ||enterococcus gallinarum ||Easy microbiology
enterococcus microbiology lecture ||enterococcus gallinarum ||Easy microbiology
 Enterococcus (E. Faecalis & E. Faecium)
Enterococcus (E. Faecalis & E. Faecium)
enterococcus microbiology lecture ||enterococcus casseliflavus ||Easy Microbiology
enterococcus microbiology lecture ||enterococcus casseliflavus ||Easy Microbiology
 ENTEROCOCCUS |Microbiology
ENTEROCOCCUS |Microbiology
 Enterococcus (Enterococci) Characterestics and Diseases | Microbiology 🧫
Enterococcus (Enterococci) Characterestics and Diseases | Microbiology 🧫